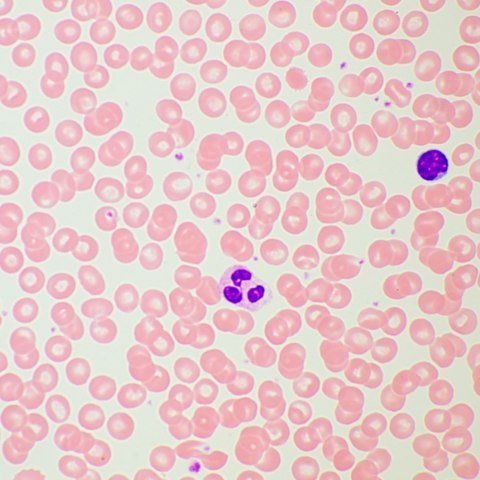
Mikroskop biologiczny MAGUS Bio 260T

Mikroskop MAGUS Bio 260T to mikroskop do codziennego użytku, który może być wykorzystywany do badań laboratoryjnych i naukowych lub do celów edukacyjnych. Mikroskop umożliwia obserwację cienkich przezroczystych i półprzezroczystych preparatów przy użyciu metody jasnego pola. W urządzeniu można jednak zainstalować dodatkowe komponenty, które rozszerzają jego możliwości i pozwalają na zastosowanie metody ciemnego pola, kontrastu fazowego, światła spolaryzowanego i fluorescencyjnego.
Model ten jest wyposażony w miskę rewolwerową z oznaczeniami, która może pomieścić pięć obiektywów. „Inteligentne" oświetlenie automatycznie zmienia się wraz z obrotem miski rewolwerowej i jest dostosowane do parametrów każdego obiektywu. Dzięki tej funkcji użytkownik nie traci czasu na regulację oświetlenia, co jest szczególnie ważne w procesie edukacyjnym lub gdy trzeba często zmieniać powiększenie.
Mikroskop ma głowicę trójokularową, która wykorzystuje system optyczny z korekcją do nieskończoności. Ustawienie wysokości źrenic można regulować. Pozycja jest regulowana poprzez obrót tub w zakresie do 360°. Kamera cyfrowa jest instalowana w tubie głowicy trójokularowej. Światło jest rozprowadzane do kamery i okularów w stosunku 50/50. Zestaw mikroskopu zawiera podstawowe okulary 10x/22 mm z mechanizmem regulacji dioptrii. Na tubach nie umieszczono mechanizmu regulacji. Użytkownicy noszący okulary korekcyjne mogą skorzystać z dołączonych gumowych muszli ocznych, które chronią szkło przed otarciami i zadrapaniami.
Miska rewolwerowa na 5 obiektywów jest wyposażona w automatyczny system sterowania oświetleniem. Podczas zmiany powiększenia użytkownik doświadcza silnych wahań poziomu oświetlenia w okularze: obiektywy o różnym powiększeniu przepuszczają światło w różny sposób. Inteligentne oświetlenie pozwala na jednorazowe ustawienie poziomu oświetlenia dla określonego obiektywu, a następnie po obróceniu miski rewolwerowej oświetlenie zmieni się automatycznie. Zestaw mikroskopu zawiera 4 obiektywy; w razie potrzeby użytkownik może umieścić obiektyw w piątym gnieździe. Odległość parafokalna wynosi 60 mm. Gniazdo nad miską rewolwerową służy do montażu analizatora; gdy analizator nie jest zainstalowany, gniazdo jest zamknięte zatyczką.
Stolik na preparaty jest wyposażony w mechanizm napędzany pasem: preparat porusza się delikatnie i płynnie. Nie ma mechanizmu zapadkowego pozycjonowania osi X, dzięki czemu praca z mikroskopem jest bardziej ergonomiczna i wygodna. Uchwyt na preparaty jest zamocowany dwoma śrubami i można go zdemontować w razie potrzeby. Kolejnym wygodnym elementem jest długi uchwyt sterujący stolikiem. Użytkownik może korzystać z mikroskopu, opierając dłonie na stoliku, bez nadwyrężania ramion i ciała.
Kondensor można ustawić w żądanym położeniu zarówno w pionie, jak i względem osi optycznej (poprzez mocowanie ze złączem płetwowym). Przysłona irysowa jest regulowana za pomocą pierścienia: ma znacznik, a wskaźniki powiększenia obiektywu są pokazane na korpusie kondensora. W przypadku obrazu kontrastowego znacznik jest ustawiany zgodnie z zainstalowanym obiektywem roboczym. Kondensor można uzupełnić o suwaki ciemnego pola lub kontrastu fazowego: umożliwia to specjalne gniazdo.
Ostrość mikroskopu ustawiana jest za pomocą współosiowo umieszczonych pokręteł zgrubnej i precyzyjnej regulacji ostrości. Zgrubna regulacja ostrości odbywa się za pomocą pokrętła po lewej stronie. Po obu stronach statywu umieszczono pokrętła do precyzyjnej regulacji ostrości, a prawe pokrętło ma specjalne, wygodne wgłębienia na palce. Dodatkową wygodę zapewnia śruba blokująca zgrubną regulację ostrości i pierścień regulacji napięcia: za pomocą pokrętła można regulować ostrość po zmianie obiektywu, a pierścień umożliwia regulację napięcia mechanizmu zgrubnej regulacji ostrości w wygodny dla użytkownika sposób. Wszystkie pokrętła i pierścień są umieszczone się w dolnej części statywu: użytkownik kontroluje je, opierając ręce wygodnie na stole.
Oświetlenie w mikroskopie jest generowane przez lampę LED o mocy 3 W zamontowaną w oświetlaczu światłem przechodzącym. Temperatura oświetlenia pozostaje stabilna nawet przy zmianach jasności. Opcjonalne metody badawcze tego mikroskopu obejmują wykorzystanie oświetlenia Köhlera. Dzięki temu całe pole preparatu jest oświetlone równomiernie, a artefakty, takie jak kurz lub obraz źródła światła, nie będą widoczne przez okular ani kamerę cyfrową.
Wybrane parametry pracy można wyświetlić i dostosować za pomocą wbudowanego wyświetlacza. Jest on umieszczony w dolnej części mikroskopu. Wyświetlacz pokazuje powiększenie obiektywu roboczego, parametry oświetlenia, tryb pracy i czas automatycznego wyłączenia.
Dodatkowe elementy mogą rozszerzyć funkcjonalność urządzenia. Zestaw okularów może zwiększyć zakres powiększenia. W przypadku dodatkowych metod pracy z preparatami, których nie można zobaczyć przy użyciu metody jasnego pola, konieczne jest uzupełnienie mikroskopu o urządzenie do kontrastu fazowego, suwak ciemnego pola lub urządzenie polaryzacyjne. Kamera cyfrowa może pomóc zarejestrować wyniki badania na zdjęciu lub filmie lub wyświetlić obraz na ekranie. Obiekty można mierzyć za pomocą preparatu kalibracyjnego w połączeniu z okularem ze skalą lub kamerą cyfrową.
Najważniejsze właściwości:
- Mikroskop jest przeznaczony do celów edukacyjnych oraz badań naukowych i laboratoryjnych
- Umożliwia obserwację przezroczystych i półprzezroczystych preparatów; oświetlacz światłem przechodzącym to lampa LED o mocy 3 W
- Oświetlenie można regulować przy użyciu metody Köhlera
- Miska rewolwerowa z oznaczeniami dostosowuje jasność oświetlenia do każdego obiektywu
- Jednocześnie można zainstalować pięć obiektywów
- Głowica trójokularowa umożliwia instalację kamery cyfrowej; dzielenie wiązki 50/50
- Odstęp źrenicy wyjściowej reguluje się poprzez obracanie tub
- Wyposażony we wbudowany wyświetlacz pokazujący parametry pracy
- Dodatkowe akcesoria pozwalają na prowadzenie badań w świetle odbitym, ciemnym polu, metodą kontrastu fazowego, fluorescencji i polaryzacji
Zawartość zestawu:
- Podstawa z wbudowanym zasilaczem, źródło światła przechodzącego, mechanizm regulacji ostrości, stolik, uchwyt kondensora i miska rewolwerowa
- Kondensor Abbego
- Głowica trójokularowa
- Obiektyw planarno-achromatyczny z korekcją do nieskończoności: 4x/0,10, wysokość parafokalna 60 mm
- Obiektyw planarno-achromatyczny z korekcją do nieskończoności: 10x/0,25, wysokość parafokalna 60 mm
- Obiektyw planarno-achromatyczny z korekcją do nieskończoności: 40x/0,65 (z mechanizmem sprężynowym), wysokość parafokalna 60 mm
- Obiektyw planarno-achromatyczny z korekcją do nieskończoności: 100x/0,25 olejowy (z mechanizmem sprężynowym), wysokość parafokalna 60 mm
- Okular 10x/22 mm z dużym odstępem źrenicy wyjściowej i regulacją dioptrii (2 szt.)
- Muszla oczna okularu (2 szt.)
- Filtr światła
- Adapter z montażem typu C
- Pojemnik z olejkiem immersyjnym
- Przewód zasilający
- Osłona przeciwkurzowa
- Instrukcja obsługi i karta gwarancyjna
Dostępne na zamówienie:
- Okular 10x/22 mm ze skalą
- Okular 10x/22 mm z celownikiem
- Okular 10x/22 mm z krzyżem
- Okular 12,5x/17,5 mm (2 szt.)
- Okular 15x/16 mm (2 szt.)
- Okular 20x/12 mm (2 szt.)
- Obiektyw planarno-achromatyczny z korekcją do nieskończoności: 20x/0,40, wysokość parafokalna 60 mm
- Urządzenie do kontrastu fazowego: zestaw suwaków kontrastu fazowego, dodatkowy teleskop wyśrodkowujący, zestaw obiektywów kontrastu fazowego
- Suwak ciemnego pola
- Oświetlacz światłem odbitym
- Urządzenia do polaryzacji
- Kamera cyfrowa
- Preparat kalibracyjny
- Monitor
| Marka |
MAGUS |
| Gwarancja |
5 лет |
| EAN |
5905555019451 |
| Rozmiar opakowania (dł. x szer. x gł.) |
47x32x67 cm |
| Masa przesyłki |
12.2 kg |
| Głowica |
trójokularowa |
| Kąt nachylenia głowicy |
30 ° |
| Powiększenie |
od 800x do 1280x |
| Średnica tubusu okularu, mm |
30 |
| Soczewki obiektywowe |
planarno-achromatyczne z korekcją do nieskończoności: 4x/0,10; 10x/0,25; 40x/0,65; 100x/1,25 olejowy (*opcjonalnie: 20x/0,40); odległość parafokalna: 60 mm |
| Rewolwer |
5 obiektywy, z oznaczeniami |
| Odległość robocza, mm |
30 (4x); 10,2 (10x); 1,5 (40xs); 0,2 (100xs) |
| Rozstaw źrenic, mm |
47 — 78 |
| Stolik, mm |
230x150 |
| Zakres ruchu stolika, z użyciem mechanizmu ustawiania ostrości, mm |
78/54 |
| Regulacja dioptrii okularu, dioptrii |
±5D w każdym okularze |
| Regulacja dioptrii okularu |
yes |
| Kondensor |
kondensor Abbego NA 1,25 z możliwością regulacji wysokości i wyśrodkowania, z regulowaną przysłoną aperturową i gniazdem z wtyczką do suwaków ciemnego pola i kontrastu fazowego; mocowanie ze złączem płetwowym |
| Diafragma |
regulowana przysłona aperturowa, regulowana przysłona irysowa pola |
| Regulacja ostrości |
współosiowy, zgrubna (30 mm, 37,7 mm/obrót, z pokrętłem blokady i pokrętłem regulacji napięcia) i precyzyjna (0,002 mm, 0,2 mm/obrót) |
| Regulacja jasności |
yes |
| Typ źródła oświetlenia |
3 W LED |
| Zakres temperatur, °C |
0 — 70 |
| Umiejscowienie źródła oświetlenia |
dolne |
| Poziom trudności składania i montażu |
skomplikowane |
| Typ |
biologiczny, lekki/optyczny |
| Głowica |
z rozkładem strumienia świetlnego 50/50, głowica typu gemel (Siedentopf, obracana w zakresie 360°) |
| Powiększenie, x |
40-1000 w konfiguracji podstawowej (*opcjonalnie: 40-1250/1500/2000) |
| Okulary |
10x/22, duży odstęp źrenicy wyjściowej (*opcjonalnie: 10x/22 ze skalą, 10x/22 z celownikiem, 10x/22 z krzyżem, 12,5x/17,5, 15x/16, 20x/12) |
| Stolik, mm |
dwuosiowy stolik mechaniczny, bez mechanizmu zapadkowego pozycjonowania osi |
| Oświetlenie |
LED |
| Zasilanie |
100—240 V, 50/60 Hz, zasilanie sieciowe AC |
| Filtry |
tak |
| Dodatkowe cechy |
automatyczna regulacja jasności podczas przełączania obiektywów, wyświetlanie statusu na ekranie LCD, tryb uśpienia, tryb ekologiczny |
| Możliwość podłączenia dodatkowych urządzeń |
suwak ciemnego pola, urządzenia do polaryzacji (polaryzator i analizator), oświetlacz światłem odbitym, urządzenie do kontrastu fazowego (suwak i obiektywy) |
| Poziom zaawansowania |
doświadczeni użytkownicy, profesjonaliści |
| Zastosowanie |
kliniczne/laboratoryjne |
| Metoda badania |
jasnego pola |
| Pokrowiec/futerał/torba w zestawie |
osłona przeciwkurzowa |
![[{[item.product.name]}]]([{[item.product.photo.url]}] 75w)